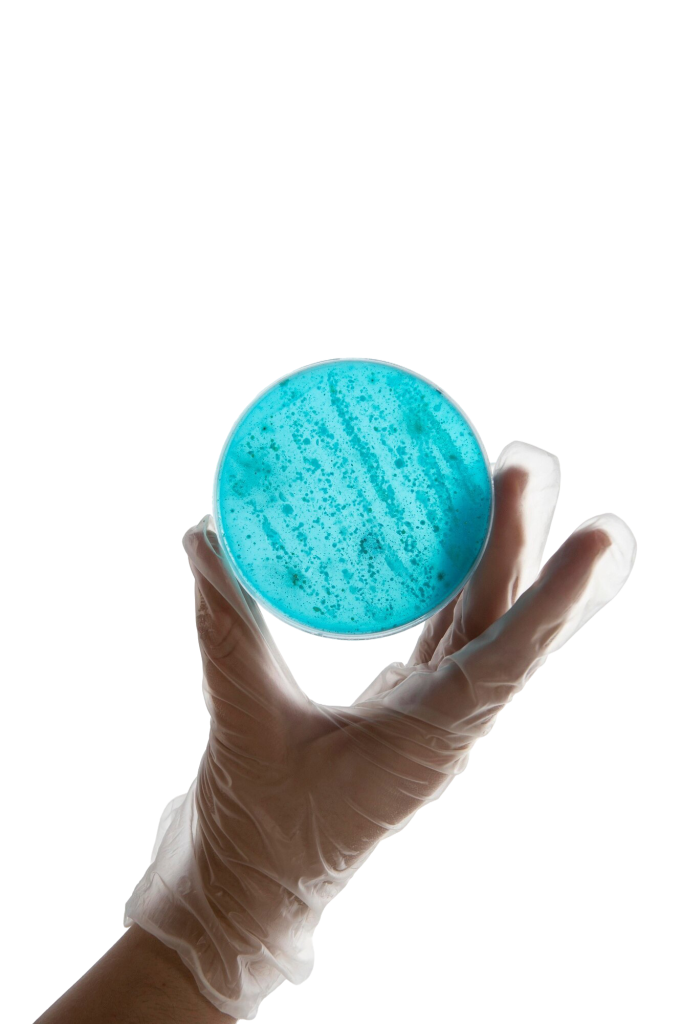
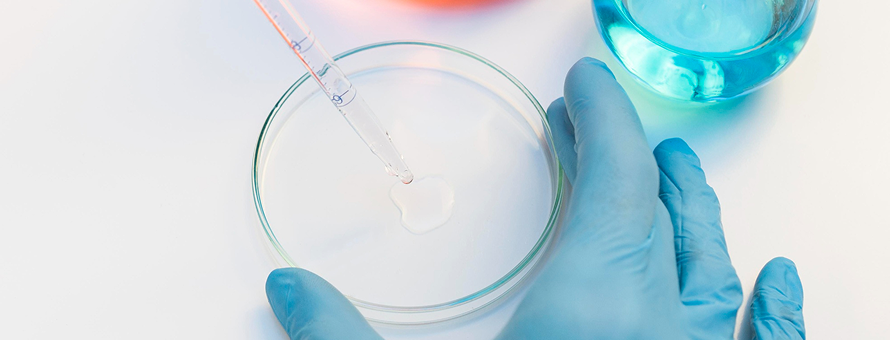

Semen Analysis
Hope Healing Happiness
in Fertility Care
A semen analysis is a test that looks at the fluid a man ejaculates (semen) to understand his ability to father a child.
Semen Analysis
What is Semen Anaysis ?
A semen analysis is a test that looks at the fluid a man ejaculates (semen) to understand his ability to father a child.
Semen is the fluid released during ejaculation. It is made up of two main parts:
- Sperm cells (produced in the testicles), which are the male reproductive cells that can fertilize a woman’s egg.
- Seminal fluid (produced by the prostate, seminal vesicles, and other glands), which helps transport and protect sperm.
Think of sperm as the “seeds” and semen as the “nutrient-rich soil and water” that help those seeds travel and survive until they meet the egg.
A semen analysis doesn’t just count sperm; it measures many qualities of the sperm and the semen fluid to see if they are healthy enough to result in a pregnancy.

When to Consider Semen Analysis
You or your doctor may consider a semen analysis when:
- A couple has been trying to conceive without success for at least one year (or six months if the female partner is 35 or older).
- To evaluate male factor infertility, which contributes to about 30–40% of infertility cases.
- After a vasectomy, to confirm that no sperm are present in the ejaculate.
Types / Parameters Measured
A standard semen analysis measures:
Macroscopic characteristics:
- Volume of ejaculate (normal: ≥1.5 mL; WHO guidelines: ~2–5 mL)
- pH (normal: ~7.2–8.0)
- Liquefaction time, color, and viscosity
Microscopic characteristics:
- Sperm concentration (≥15 million/mL; WHO: ≥20 million/mL)
- Total sperm count (WHO: ≥40 million per ejaculate)
- Motility (≥40–50% moving; ≥25% showing rapid forward progression within 60 minutes)
- Morphology (normal shapes; WHO: ≥4–50%, depending on criteria)
- Viability (≥75% alive)
- White blood cells presence (≤1 million/mL)
- Fructose levels (indicator of seminal vesicle health)
Step Process
Procedure
Step 1 : Preparation
- Abstain from ejaculation for 2–7 days.
- Avoid heat exposure (like hot tubs) and lifestyle factors such as excessive smoking or alcohol before the test.
- Multiple samples (at least two, spaced weeks apart) are recommended for accuracy.
Step 2 : Sample Collection
- Usually collected via masturbation into a sterile container, ideally at the clinic; alternatives include home collection if delivered promptly.
Step 3 : Laboratory Analysis
- Lab evaluates both macroscopic and microscopic features under quality-controlled settings, following WHO standards.
- Advanced methods like computer-assisted sperm analysis (CASA) improve accuracy.
Results
Normal values
- Volume: ≥1.5 mL
- Concentration: ≥15 million/mL
- Motility: ≥40–50%
- Morphology (normal): ≥4%
Abnormal findings can suggest issues
- Low count (oligospermia)
- Poor motility (asthenozoospermia)
- Abnormal shape (teratozoospermia)
- Signs of infection, obstruction, or hormonal imbalance
Interpretation
- An abnormal result doesn’t necessarily confirm infertility—repeat testing is essential.
- Results guide further evaluation and help tailor fertility treatments like lifestyle changes, medications, surgery, or ART (e.g., IUI, IVF, ICSI).

